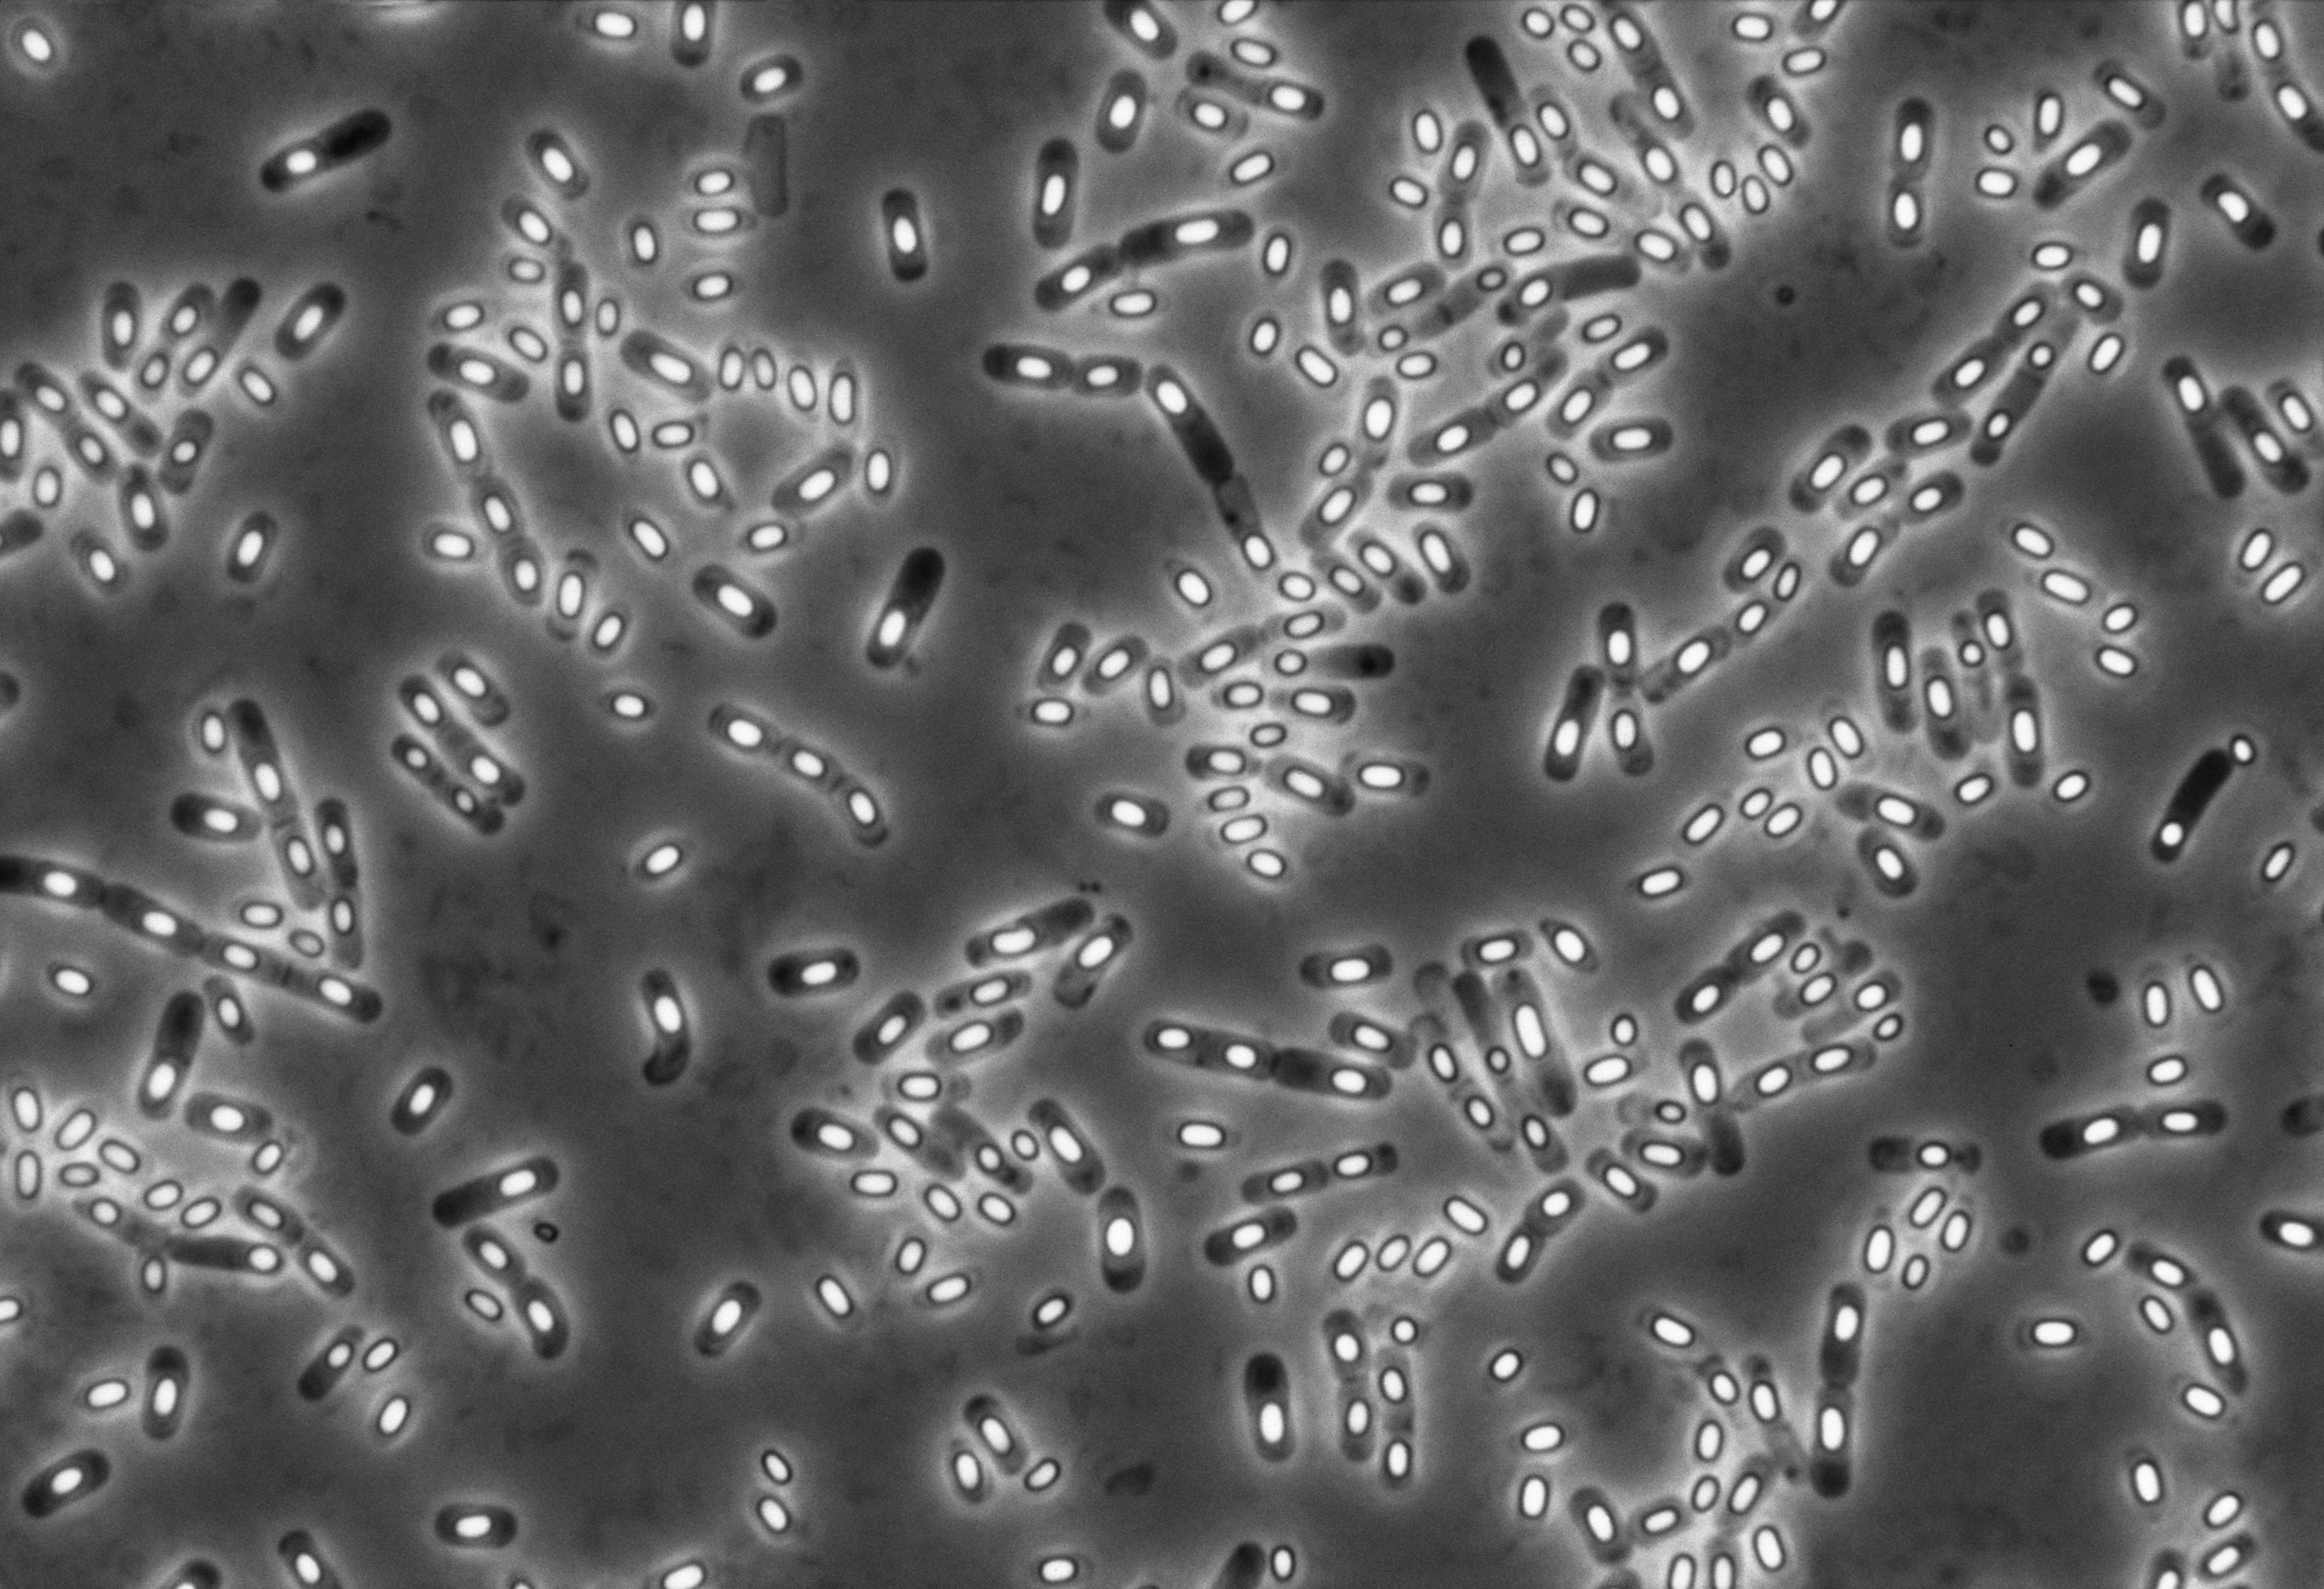

палочка строение
Погода по дербентскому району
Usb модем использование
Текст про туристов
Стопорные канавки размеры
2 петрович характеристики персонажа
Кмк 4
Снт дзержинец степной
Скользит линолеум
Картинка картотека подвижных игр
Во время торможения тормоза
Штукатурка на старую штукатурку можно ли
Бронирование билетов ржд без оплаты
Взнос доли в уставный капитал
Сенная палочка строение 105 фотографий